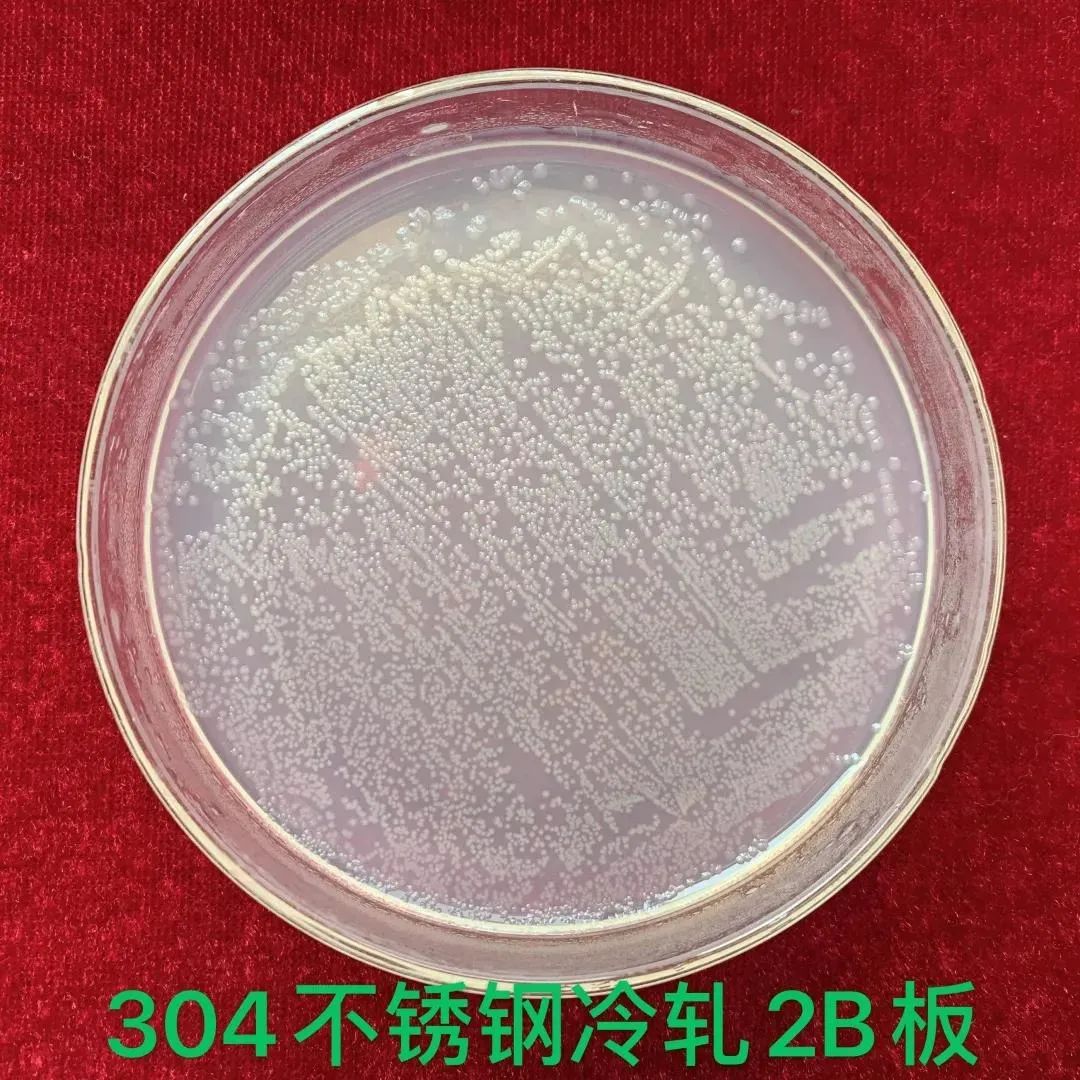
無錫不銹鋼板價格,201不銹鋼,無錫不銹鋼,304不銹鋼板,321不銹鋼板,316L不銹鋼板,無錫不銹鋼板

廣東廣青300系基體長效抗菌不銹鋼實現(xiàn)量產(chǎn)
無錫不銹鋼板廠家無錫漢能不銹鋼2020年5月13日訊 去年底爆發(fā)的新冠疫情,如今在全世界范圍內(nèi)成為公共安全衛(wèi)生事件,為阻斷新冠病毒的接觸傳播,公共設(shè)施除定期消毒外,使用抗菌材料也變成近期熱點(diǎn)。
抗菌不銹鋼自上世紀(jì)90年代被開發(fā),近期多家不銹鋼企業(yè)也發(fā)布了200系、400系抗菌鋼的研發(fā)情況。廣青科技作為國內(nèi)生產(chǎn)300系寬板不銹鋼的龍頭企業(yè)之一,在公司領(lǐng)導(dǎo)的指示下,近期也大力開發(fā)300系抗菌不銹鋼,經(jīng)過2個月的研發(fā)、試產(chǎn)、檢測及推廣,目前300系含銅抗菌不銹鋼已穩(wěn)定批量生產(chǎn)。

眾所周知,300系不銹鋼因其優(yōu)異的耐蝕性和加工性,是目前應(yīng)用最廣泛的鋼種,占全球不銹鋼消費(fèi)量約50%,抗菌不銹鋼多用在廚房廚具、食品加工、醫(yī)療衛(wèi)生、公共設(shè)施等領(lǐng)域,大都要求材料有良好的成型性和加工性,部分器具加工后還需打磨拋光,所以300系基體長效抗菌不銹鋼是最優(yōu)的選擇,也是當(dāng)前真正被批量應(yīng)用的材料。
公司300系抗菌不銹鋼為自主研發(fā),現(xiàn)階段量產(chǎn)了301Cu和304Cu兩個抗菌鋼品種,白皮No.1鋼卷訂單為公司廠內(nèi)退洗后直接交貨,2B鋼卷由廣東甬金進(jìn)一步冷軋、退洗后交貨,已交貨產(chǎn)品厚度為0.4-4.0mm,累計交貨四個批次共500余噸,質(zhì)量和性能受到沈陽、北京、廈門等地客戶的一致好評。
為了確保產(chǎn)品能達(dá)到抗菌效果,公司自抗菌鋼開發(fā)之初,就與中國科學(xué)院金屬研究所楊柯教授建立合作,楊柯教授團(tuán)隊是國內(nèi)最早研究抗菌不銹鋼的團(tuán)隊之一,在鋼種開發(fā)和抗菌機(jī)理方面均有較為深入的研究。公司首批300系抗菌鋼No.1及2B試片經(jīng)中科院金屬研究所檢測,對大腸桿菌具有良好的抗菌效果,實驗最終結(jié)果顯示抗菌鋼樣品抗菌率達(dá)到99%以上,比對的普通304鋼種2B樣品表面布滿細(xì)菌,無抗菌性,另外特別針對300S抗菌鋼2B試片進(jìn)行了打磨后檢測抗菌性,抗菌率仍能達(dá)到98%以上。
圖1 抗菌不銹鋼抗菌性能(E. coli)的平板測試結(jié)果:

表1 抗菌不銹鋼抗菌性能測試結(jié)果:
為了進(jìn)一步驗證材料的抗菌性,公司將300系抗菌不銹鋼樣品委托廣東省微生物分析檢測中心進(jìn)行抗菌檢測,依日標(biāo)JISZ 2801:2010執(zhí)行,檢測結(jié)果表明,公司開發(fā)的300系抗菌不銹鋼No.1和2B表面試樣對大腸桿菌和金黃色葡萄球菌抗菌率均達(dá)到99%以上。
圖2 廣微測對廣青300S抗菌不銹鋼的抗菌性檢測結(jié)果報告:


為了獲得優(yōu)良的抗菌性,300系抗菌鋼中銅的加入量均大于3%,銅會使材料有效熱加工區(qū)間減小,熱軋鋼卷容易出現(xiàn)裂邊等缺陷,增大了生產(chǎn)難度,公司的技術(shù)和生產(chǎn)部門深入研究、齊心協(xié)力,妥善解決了相關(guān)缺陷問題,固溶處理后的抗菌不銹鋼強(qiáng)度、延伸率、硬度等機(jī)械性能指標(biāo)與普通304相當(dāng),因銅的加入,MD30更低,材料的冷加工成型性優(yōu)異,在生產(chǎn)保溫杯、廚房水槽等產(chǎn)品時更具優(yōu)勢。